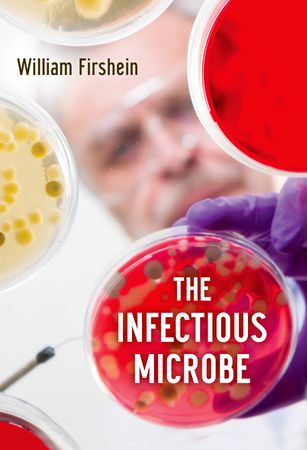

MORE ABOUT THIS BOOK
Main description:
Of the almost innumerable interactions between science and humanity, few are as central or as significant as microorganisms. These single-celled "complete" living organisms are intimately involved with life and must be taken into account in many ways when considering the welfare and health of the public. Though microorganisms have major impacts on many chemical and ecological processes, they are most often recognized for their ability to cause serious and sometimes
fatal diseases. From diseases caused by bacteria like pneumonia, tuberculosis, anthrax, meningitis, typhoid, and bubonic plague, to diseases caused by viruses like HIV, polio, yellow fever, hepatitis, and influenza, humanity has struggled to cope with their rapidly changing capabilities. This book is
a response to current confusion and misunderstanding of microbes amongst the general public; written in narrative form, it will allow readers to better understand the scientific concepts and terminology of how microbial or viral diseases are caused, to ask intelligent questions about the impact of such diseases on our wellbeing, and to comprehend reports about disease outbreaks that flood the media. Following several introductory chapters that introduce the microbe, its history, and the
necessary fundamental chemical and biological concepts, the heart of the book describes in great detail six critical microbial and viral diseases that plague our world and how each of them illustrates the basic characteristics of infection. Each of these six diseases follows the same path-invasion, internal
spread, toxin effects, and excretion-and an understanding of the pathogenicity of each will provide readers with a better understanding of the fascinating scientific relationship between man and virus, human and microbe, and how to live with or defeat them.
Contents:
PREFACE ; CHAPTER 1. INTRODUCTION TO THE INFECTIOUS MICROBE ; A. The Scope of Microbial Life and Infectious Diseases ; B. What Is a Pathogen? ; C. The Relationship Between a Pathogen and the Host It Infects Is Complex and Varied ; D. Susceptibility and Virulence Factors Are Closely Related ; E. Major Groups of Pathogens Are Found Throughout the Microbial World ; CHAPTER II. FUNDAMENTAL CONCEPTS OF BIOLOGY AND CHEMISTRY HELP UNDERSTAND PATHOGENICITY ; A. Genetics: The Nature of the Gene and Its Chemical Structure (DNA) ; B. Metabolism Consists of Chemical Reactions Without Which Life Would Not Exist ; C. Biological Catalysts (Enzymes) Mediate Every Chemical Reaction in the Cell ; D. Genes Control the Synthesis and Expression of Enzymes (Which Are Proteins) and Hence Control the Functioning of the Cell ; E. The Mechanism of Protein Synthesis Involves a Complex Series of Metabolic Reactions and Cellular Organelles Starting with DNA, a Related Macromolecule, RNA, and the Ribosome (the Protein Synthesizing Factory) ; F. Gene Expression is Tightly Regulated to Economize and Preserve Cell Integrity ; G. Genetic Modifications in the Process of Gene Expression in Microbes Are Varied and Complex. They Include Mutations, Transfer Transformation (Recombination) of Genes From One Cell to Another, and Many Other Variations of These Events ; H. Modern Technologies ; CHAPTER III. HISTORY OF MICROBIOLOGY ; A. Voices in the Wilderness ; B. The Golden Age and Modern Era ; CHAPTER IV. EMERGING AND REEMERGING DISEASES ; A. Introduction ; B. Definitions ; C. Examples of Each ; D. Role of Antibiotics ; CHAPTER V. CASE HISTORIES ; A. Introduction: Why Are the Following Examples Chosen? ; B. HIV-AIDS - The Plague That Threatens Modern Society ; 1) Origins ; 2) Characteristics ; 3) Versatility ; 4) Structure of Genome ; 5) Treatment ; 6) Course of Infection ; 7) Conclusions ; C. Tuberculosis - The White Plague, Ancient, But Still Lethal ; 1) Introduction ; 2) Description ; 3) Pathogenicity ; 4) Testing and Virulence Factors ; 5) Treatment ; D. Streptococci and Staphylococci: More Intimacy Than We Desire ; 1) Introduction ; 2) General Descriptions ; 3) Staphylococci ; 4) Toxins ; 5) Staph Diseases ; 6) Treatment ; 7) Streptococci ; 8) Toxins ; 9) Other Streptococci ; E. Ulcers and Helicobacter - The Uncommon Pathogen ; 1) Introduction ; 2) The Organism ; 3) The Disease ; 4) Pathogenicity ; 5) Toxins ; 6) Treatment ; F. Cholera - A Pretty Nasty Beast ; 1) Introduction ; 2) The Organism ; 3) Pathogencity ; 4) Diagnosis, Prevention and Treatment of Cholera ; 5) The Agony of Haiti ; 6) Conclusions ; G. Influenza - Bird Flu, Swine Flu and All That Jazz ; 1) Introduction ; 2) The Virus and Pathogenicity ; 3) Spread, Prevention and Treatment ; 4) Conclusion ; CHAPTER VI. BIOFILMS: CITY OF MICROBES AND THEIR ROLE IN PATHOGENCITY ; A. Introduction ; B. Biofilms and Infectious Diseases ; CHAPTER VII. BIOLOGICAL TERRORISM - MYTHS AND REALITIES ; A. Introduction ; B. Historical Perspective ; C. Bioterrorism Today: State of the Art and Preparedness ; D. Conclusions ; GLOSSARY ; A. Scientists ; B. Definitions ; PHOTO CREDITS
PRODUCT DETAILS
Publisher: Oxford University Press (Oxford University Press Inc)
Publication date: February, 2014
Pages: 176
Dimensions: 156.00 x 236.00 x 18.00
Weight: 460g
Availability: Available
Subcategories: Immunology, Infectious Diseases, Microbiology